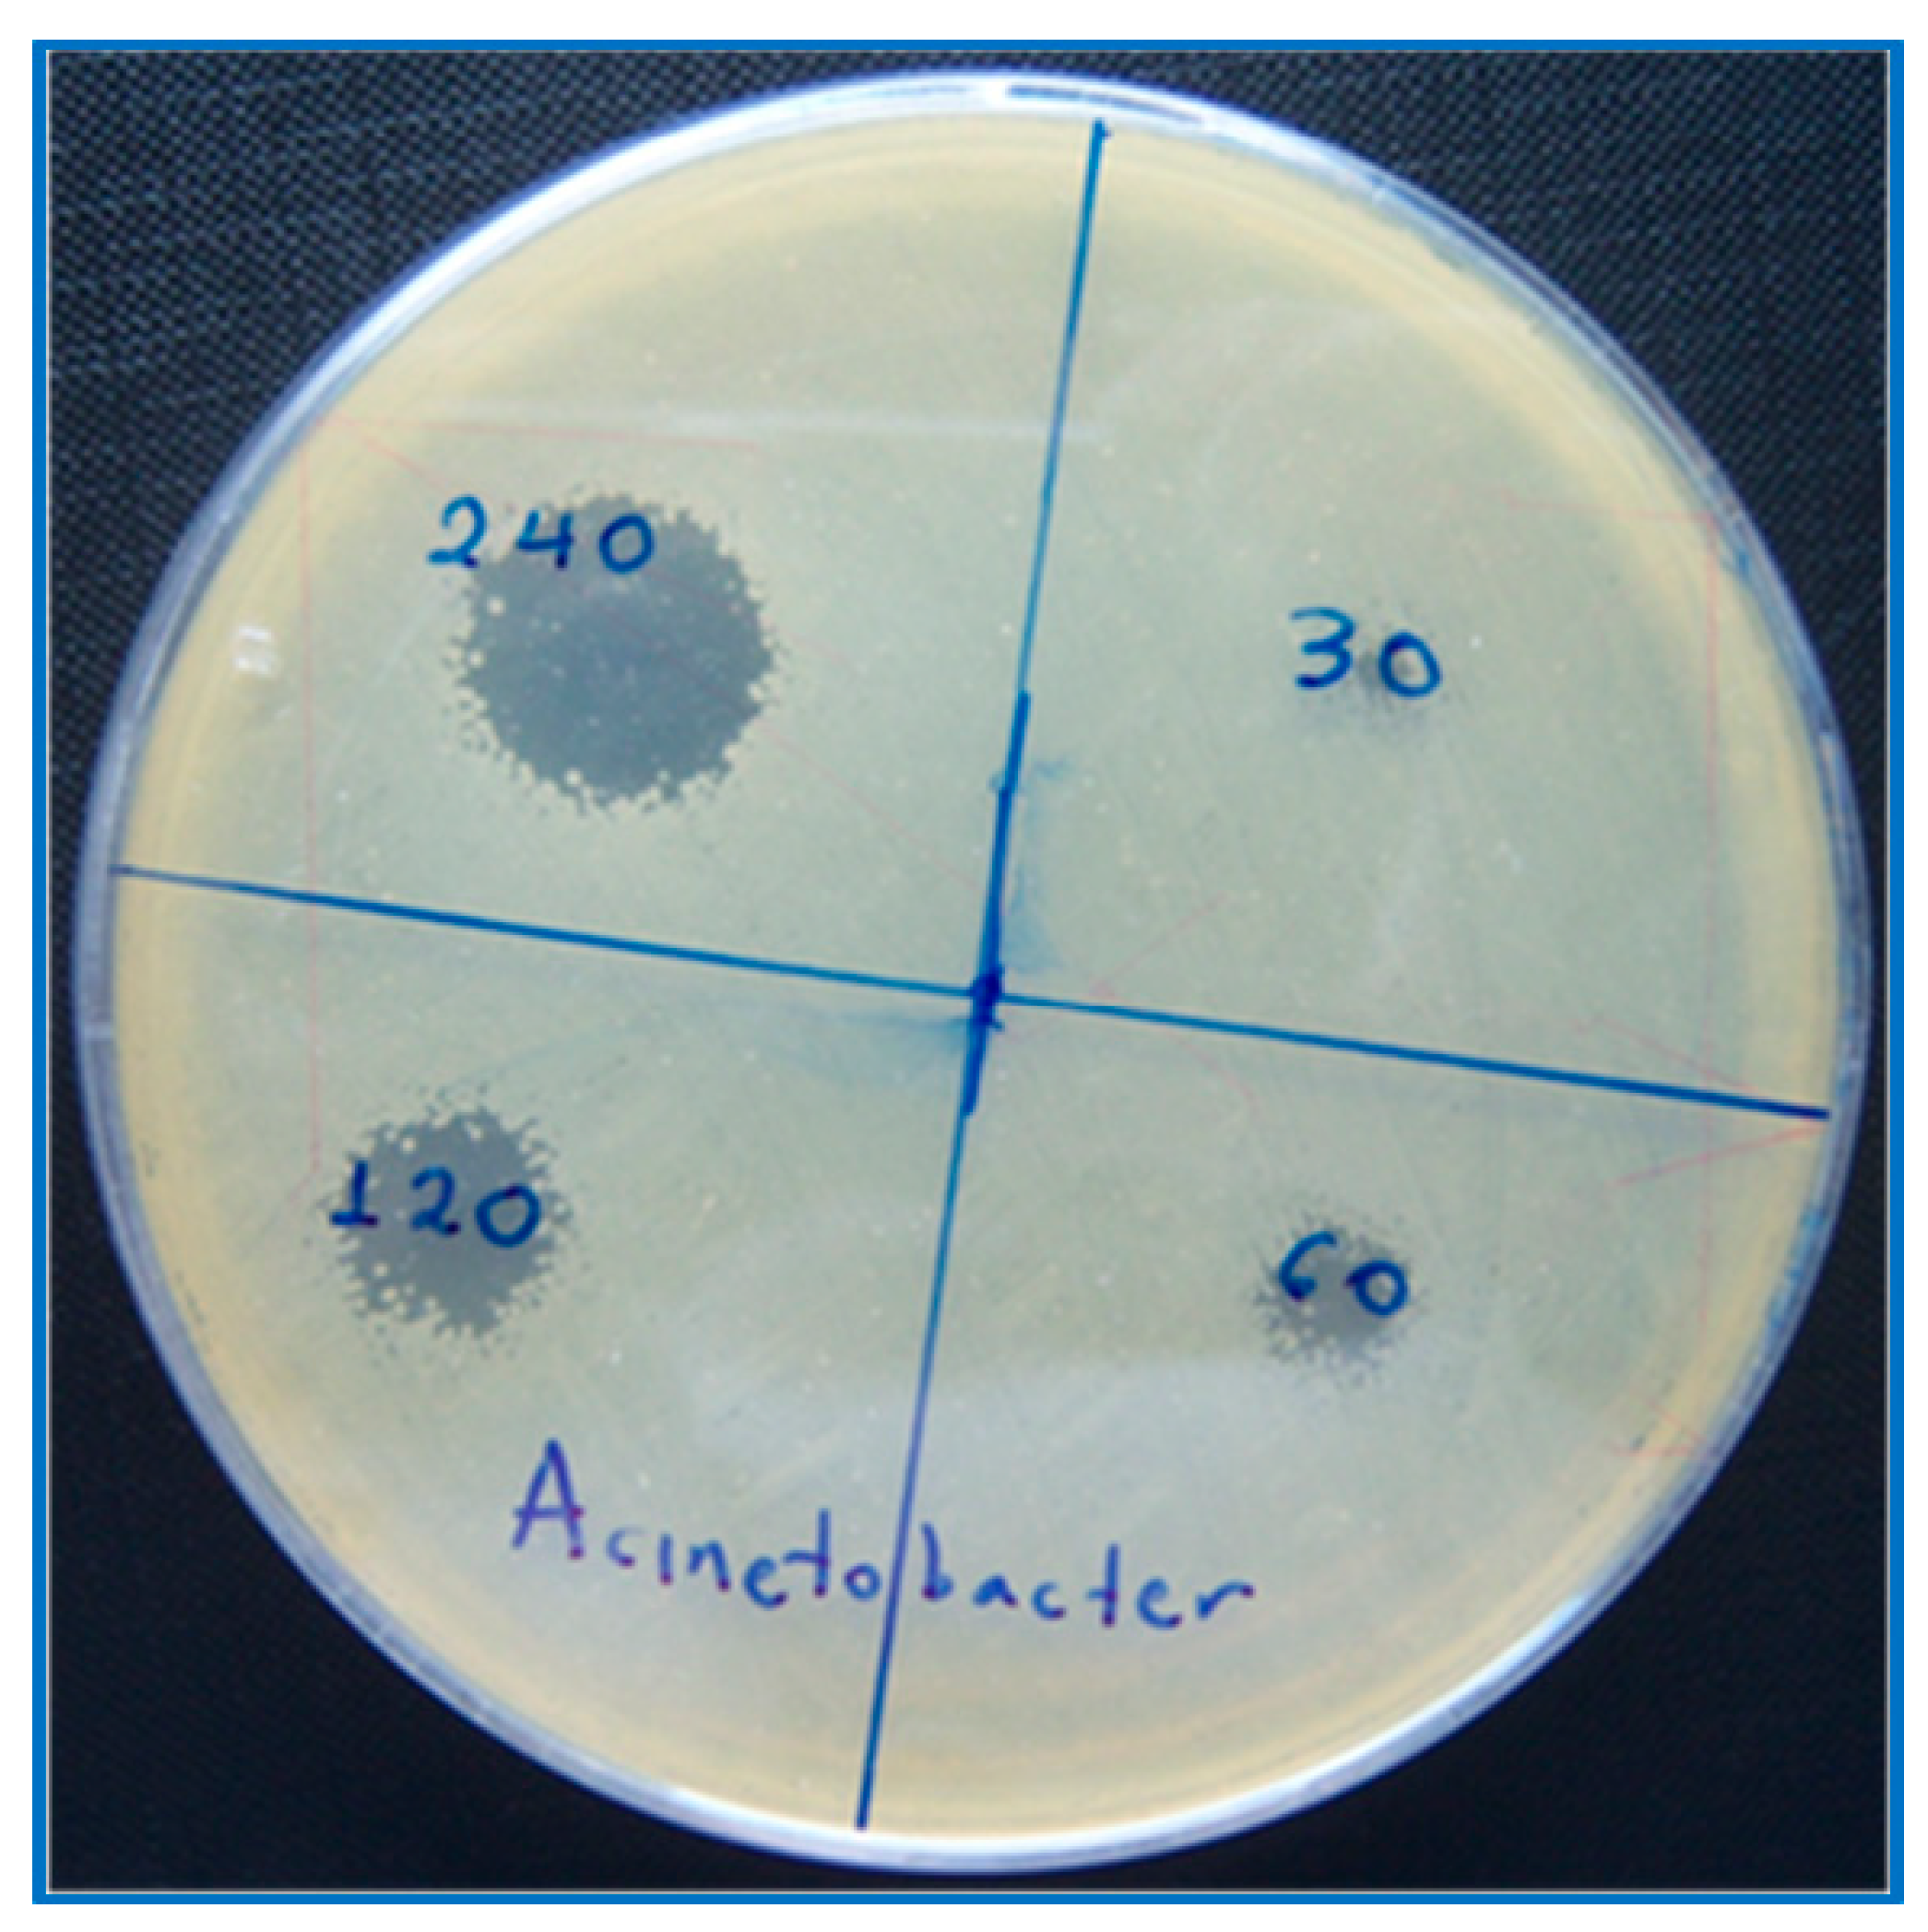
Plasma 02 00008 g004

Acinetobacter baumannii Deactivation by Means of DBD-Based Helium Plasma Jet
Abstract
:1. Introduction
2. Experimental Setup and Specimens
2.1. Plasma Setup
2.2. Bacteria Preparation and Treatment
2.3. Growth Inhibition Zone Experiments
2.4. Scanning Electron Microscopy of Bacteria
3. Results and Discussion
4. Conclusions
Author Contributions
Funding
Conflicts of Interest
References
- Lu, X.; Laroussi, M.; Puech, V. On atmospheric-pressure non-equilibrium plasma jets and plasma bullets. Plasma Sources Sci. Technol. 2012, 21, 34005. [Google Scholar] [CrossRef]
- Lu, X.; Naidis, G.V.; Laroussi, M.; Ostrikov, K. Guided ionization waves: Theory and experiments. Phys. Rep. 2014, 540, 123–166. [Google Scholar] [CrossRef]
- Boeuf, J.-P.; Yang, L.L.; Pitchford, L.C. Dynamics of a guided streamer (“plasma bullet”) in a helium jet in air at atmospheric pressure. J. Phys. D Appl. Phys. 2013, 46, 015201. [Google Scholar] [CrossRef]
- Gazeli, K.; Svarnas, P.; Vafeas, P.; Papadopoulos, P.K.; Gkelios, A.; Clément, F. Investigation on streamers propagating into a helium jet in air at atmospheric pressure: Electrical and optical emission analysis. J. Appl. Phys. 2013, 114, 103304. [Google Scholar] [CrossRef]
- Gazeli, K.; Svarnas, P.; Held, B.; Marlin, L.; Clément, F. Possibility of controlling the chemical pattern of He and Ar “guided streamers” by means of N2 or O2 additives. J. Appl. Phys. 2015, 117, 93302. [Google Scholar] [CrossRef]
- Gazeli, K.; Doanh, T.L.; Held, B.; Clément, F. Electrical, thermal and optical parametric study of guided ionization waves produced with a compact μs-pulsed DBD-based reactor. Plasma 2018, 1, 23–44. [Google Scholar] [CrossRef]
- Teschke, M.; Kedzierski, J.; Finantu-Dinu, E.G.; Korzec, D.; Engemann, J. High-speed photographs of a dielectric barrier atmospheric pressure plasma jet. IEEE Trans. Plasma Sci. 2005, 33, 310–311. [Google Scholar] [CrossRef]
- Karakas, E.; Koklu, M.; Laroussi, M. Correlation between helium mole fraction and plasma bullet propagation in low temperature plasma jets. J. Phys. D Appl. Phys. 2010, 43, 155202. [Google Scholar] [CrossRef]
- Robert, E.; Darny, T.; Dozias, S.; Iseni, S.; Pouvesle, J.M. New insights on the propagation of pulsed atmospheric plasma streams: From single jet to multi jet arrays. Phys. Plasmas 2015, 22, 122007. [Google Scholar] [CrossRef]
- Robert, E.; Barbosa, E.; Dozias, S.S.; Vandamme, M.; Cachoncinlle, C.; Viladrosa, R.; Pouvesle, J.M. Experimental Study of a Compact Nanosecond Plasma Gun. Plasma Process. Polym. 2009, 6, 795–802. [Google Scholar] [CrossRef]
- Douat, C.; Bauville, G.; Fleury, M.; Laroussi, M.; Puech, V. Dynamics of colliding microplasma jets. Plasma Sources Sci. Technol. 2012, 21, 34010. [Google Scholar] [CrossRef]
- Svarnas, P.; Gazeli, K.; Gkelios, A.; Amanatides, E.; Mataras, D. On the reliable probing of discrete ‘plasma bullet’ propagation. Meas. Sci. Technol. 2018, 29, 045016. [Google Scholar] [CrossRef] [Green Version]
- Papadopoulos, P.K.; Vafeas, P.; Svarnas, P.; Gazeli, K.; Hatzikonstantinou, P.M.; Gkelios, A.; Clément, F. Interpretation of the gas flow field modification induced by guided streamer (“plasma bullet”) propagation. J. Phys. D Appl. Phys. 2014, 47, 425203. [Google Scholar] [CrossRef]
- Darny, T.; Pouvesle, J.-M.; Fontane, J.; Joly, L.; Dozias, S.; Robert, E. Plasma action on helium flow in cold atmospheric pressure plasma jet experiments. Plasma Sources Sci. Technol. 2017, 26, 105001. [Google Scholar] [CrossRef] [Green Version]
- Logothetis, D.K.; Papadopoulos, P.K.; Svarnas, P.; Vafeas, P. Numerical simulation of the interaction between helium jet flow and an atmospheric-pressure “plasma jet”. Comput. Fluids 2016, 140, 11–18. [Google Scholar] [CrossRef]
- Darny, T.; Pouvesle, J.-M.; Puech, V.; Douat, C.; Dozias, S.; Robert, E. Analysis of conductive target influence in plasma jet experiments through helium metastable and electric field measurements. Plasma Sources Sci. Technol. 2017, 26, 45008. [Google Scholar] [CrossRef]
- Douat, C.; Kacem, I.; Sadeghi, N.; Bauville, G.; Fleury, M.; Puech, V. Space-time resolved density of helium metastable atoms in a nanosecond pulsed plasma jet: Influence of high voltage and pulse frequency. J. Phys. D Appl. Phys. 2016, 49, 285204. [Google Scholar] [CrossRef]
- Hübner, S.; Santos Sousa, J.; Puech, V.; Kroesen, G.M.W.; Sadeghi, N. Electron properties in an atmospheric helium plasma jet determined by Thomson scattering. J. Phys. D Appl. Phys. 2014, 47, 432001. [Google Scholar] [CrossRef] [Green Version]
- Damany, X.; Pasquiers, S.; Blin-Simiand, N.; Bauville, G.; Bournonville, B.; Fleury, M.; Jeanney, P.; Santos Sousa, J. Impact of an atmospheric argon plasma jet on a dielectric surface and desorption of organic molecules. Eur. Phys. J. Appl. Phys. 2016, 75, 24713. [Google Scholar] [CrossRef]
- Wang, T.; Yang, B.; Chen, X.; Wang, X.; Yang, C.; Liu, J. Distinct modes in the evolution of interaction between polymer film and atmospheric pressure plasma jet. Plasma Process. Polym. 2017, 14, e1600067. [Google Scholar] [CrossRef]
- Babayan, S.E.; Jeong, J.Y.; Schütze, A.; Tu, V.J.; Moravej, M.; Selwyn, G.S.; Hicks, R.F. Deposition of silicon dioxide films with a non-equilibrium atmospheric-pressure plasma jet. Plasma Sources Sci. Technol. 2001, 10, 573–578. [Google Scholar] [CrossRef]
- Szili, E.J.; Al-Bataineh, S.A.; Bryant, P.M.; Short, R.D.; Bradley, J.W.; Steele, D.A. Controlling the spatial distribution of polymer surface treatment using atmospheric-pressure microplasma jets. Plasma Process. Polym. 2011, 8, 38–50. [Google Scholar] [CrossRef]
- Misra, N.N.; Schluter, O.K.; Cullen, P.J. Cold Plasma in Food and Agriculture–Fundamentals and Applications; Academic Press: Cambridge, MA, USA, 2016; ISBN 9780128013656. [Google Scholar]
- Iza, F.; Kim, G.J.; Lee, S.M.; Lee, J.K.; Walsh, J.L.; Zhang, Y.T.; Kong, M.G. Microplasmas: Sources, particle kinetics, and biomedical applications. Plasma Process. Polym. 2008, 5, 322–344. [Google Scholar] [CrossRef]
- Von Woedtke, T.; Reuter, S.; Masur, K.; Weltmann, K.-D. Plasmas for medicine. Phys. Rep. 2013, 530, 291–320. [Google Scholar] [CrossRef]
- Tanaka, H.; Ishikawa, K.; Mizuno, M.; Toyokuni, S.; Kajiyama, H.; Kikkawa, F.; Metelmann, H.-R.; Hori, M. State of the art in medical applications using non-thermal atmospheric pressure plasma. Rev. Mod. Plasma Phys. 2017, 1, 3. [Google Scholar] [CrossRef] [Green Version]
- Girard, P.-M.; Arbabian, A.; Fleury, M.; Bauville, G.; Puech, V.; Dutreix, M.; Sousa, J.S. Synergistic effect of H2O2 and NO2 in cell death induced by cold atmospheric He plasma. Sci. Rep. 2016, 6, 29098. [Google Scholar] [CrossRef] [PubMed]
- Girard, F.; Badets, V.; Blanc, S.; Gazeli, K.; Marlin, L.; Authier, L.; Svarnas, P.; Sojic, N.; Clément, F.; Arbault, S. Formation of reactive nitrogen species including peroxynitrite in physiological buffer exposed to cold atmospheric plasma. RSC Adv. 2016, 6, 78457–78467. [Google Scholar] [CrossRef]
- Svarnas, P.; Matrali, S.H.; Gazeli, K.; Antimisiaris, S.G. Assessment of atmospheric-pressure guided streamer (plasma bullet) influence on liposomes with different composition and physicochemical properties. Plasma Process. Polym. 2015, 7, 655–665. [Google Scholar] [CrossRef]
- Svarnas, S.; Matrali, H.; Gazeli, K.; Aleiferis, S.; Clément, F.; Antimisiaris, S.G. Atmospheric-pressure guided streamers for liposomal membrane disruption. Appl. Phys. Lett. 2012, 101, 264103. [Google Scholar] [CrossRef]
- Athanasopoulos, D.; Svarnas, P.; Ladas, S.; Kennou, S.; Koutsoukos, P. On the wetting properties of human epidermidis surface exposed to cold atmospheric-pressure pulsed plasma. Appl. Phys. Lett. 2018, 112, 213703. [Google Scholar] [CrossRef]
- Svarnas, P.; Papadopoulos, P.K.; Athanasopoulos, D.; Sklias, K.; Gazeli, K.; Vafeas, P. Parametric study of thermal effects in a capillary deilectric-barrier discharge related to plasma jet production: Experiments and nuemrical modelling. J. Appl. Phys. 2018, 124, 064902. [Google Scholar] [CrossRef]
- Graves, D.B. The emerging role of reactive oxygen and nitrogen species in redox biology and some implications for plasma applications to medicine and biology. J. Phys. D Appl. Phys. 2012, 45, 263001. [Google Scholar] [CrossRef]
- Gazeli, K.; Bauville, G.; Fleury, M.; Jeanney, P.; Neveu, O.; Pasquiers, S.; Snatos Sousa, J. Effect of the gas flow rate on the spatiotemporal distribution of Ar(1s5) absolute densities in a ns pulsed plasma jet impinging on a glass surface. Plasma Sources Sci. Technol. 2018, 27, 065003. [Google Scholar] [CrossRef] [Green Version]
- Raoult, D.; Richet, H. Nosocimial bacteraemia: The most neglected causes of death in Europe? Clin. Microbiol. Infect. 2011, 17, 1123. [Google Scholar] [CrossRef]
- Martines, E.; Zuin, M.; Cavazzana, R.; Gazza, E.; Serianni, G.; Spagnolo, S.; Spolaore, M.; Leonardi, A.; Deligianni, V.; Brun, P.; et al. A novel plasma source for sterilization of living tissues. New J. Phys. 2009, 11, 115014. [Google Scholar] [CrossRef]
- Choi, J.H.; Han, I.; Baik, H.K.; Lee, M.H.; Han, D.-W.; Park, J.-C.; Lee, I.-S.; Song, K.M.; Lim, Y.S. Analysis of sterilization effect by pulsed dielectric barrier discharge. J. Electrost. 2006, 64, 17–22. [Google Scholar] [CrossRef]
- Weltmann, K.-D.; Brandenburg, R.; von Woedtke, T.; Ehlbeck, J.; Foest, R.; Stieber, M.; Kindel, E. Antimicrobial treatment of heat sensitive products by miniaturized atmospheric pressure plasma jets (APPJs). J. Phys. D Appl. Phys. 2008, 41, 194008. [Google Scholar] [CrossRef]
- Ayan, H.; Staack, D.; Fridman, G.; Gutsol, A.; Mukhin, Y.; Starikovskii, A.; Fridman, A.; Friedman, G. Application of nanosecond-pulsed dielectric barrier discharge for biomedical treatment of topographically non-uniform surfaces. J. Phys. D Appl. Phys. 2009, 42, 125202. [Google Scholar] [CrossRef]
- Isbary, G.; Morfill, G.; Schmidt, H.U.; Georgi, M.; Ramrath, K.; Heinlin, J.; Karrer, S.; Landthaler, M.; Shimizu, T.; Steffes, B.; et al. A first prospective randomized controlled trial to decrease bacterial load using cold atmospheric argon plasma on chronic wounds in patients. Br. J. Dermatol. 2010, 163, 78–82. [Google Scholar] [CrossRef]
- Sladek, R.E.J.; Stoffels, E. Deactivation of Escherichia coli by the plasma needle. J. Phys. D Appl. Phys. 2005, 38, 1716–1721. [Google Scholar] [CrossRef]
- Park, B.J.; Takatori, K.; Lee, M.H.; Han, D.-W.; Woo, Y.I.; Son, H.J.; Kim, J.K.; Chung, K.-H.; Hyun, S.O.; Park, J.-C. Escherichia coli sterilization and lipopolysaccharide inactivation using microwave-induced argon plasma at atmospheric pressure. Surf. Coat. Technol. 2007, 201, 5738–5741. [Google Scholar] [CrossRef]
- Cao, Y.; Yang, P.; Lu, X.; Xiong, Z.; Ye, T.; Xiong, Q.; Sun, Z. Efficacy of atmospheric pressure plasma as an antibacterial agent against enterococcus faecalis in vitro. Plasma Sci. Technol. 2011, 13, 93–98. [Google Scholar] [CrossRef]
- Lee, K.-Y.; Park, B.J.; Lee, D.H.; Lee, I.-S.; Hyun, S.O.; Chung, K.-H.; Park, J.-C. Sterilization of Escherichia coli and MRSA using microwave-induced argon plasma at atmospheric pressure. Surf. Coat. Technol. 2004, 193, 35–38. [Google Scholar] [CrossRef]
- Ekem, N.; Akan, T.; Akgun, Y.; Kiremitci, A.; Pat, S.; Musa, G. Sterilization of Staphylococcus aureus by atmospheric pressure pulsed plasma. Surf. Coat. Technol. 2006, 201, 993–997. [Google Scholar] [CrossRef]
- Sun, Y.; Yu, S.; Sun, P.; Wu, H.; Zhu, W.; Liu, W.; Zhang, J.; Fang, J.; Li, R. Inactivation of Candida biofilms by non-thermal plasma and its enhancement for fungistatic effect of antifungal drugs. PLoS ONE 2012, 7, e40629. [Google Scholar] [CrossRef] [PubMed]
- Boudam, M.K.; Moisan, M.; Saoudi, B.; Popovici, C.; Gherardi, N.; Massines, F. Bacterial spore inactivation by atmospheric-pressure plasmas in the presence or absence of UV photons as obtained with the same gas mixture. J. Phys. D Appl. Phys. 2006, 39, 3494–3507. [Google Scholar] [CrossRef]
- Fridman, G.; Brooks, A.D.; Balasubramanian, M.; Fridman, A.; Gutsol, A.; Vasilets, V.N.; Ayan, H.; Friedman, G. Comparison of direct and indirect effects of non-thermal atmospheric-pressure plasma on bacteria. Plasma Process. Polym. 2007, 4, 370–375. [Google Scholar] [CrossRef]
- Fridman, G.; Peddinghaus, M.; Ayan, H.; Fridman, A.; Balasubramanian, M.; Gutsol, A.; Brooks, A.; Friedman, G. Blood coagulation and living tissue sterilization by floating-electrode dielectric barrier discharge in air. Pure Appl. Chem. 2006, 26, 425–442. [Google Scholar]
- Laroussi, M.; Tendero, C.; Lu, X.; Alla, S.; Hynes, W.L. Inactivation of bacteria by the plasma pencil. Plasma Process. Polym. 2006, 3, 470–473. [Google Scholar] [CrossRef]
- Kvam, E.; Davis, B.; Mondello, F.; Garner, A.L. Nonthermal atmospheric plasma rapidly disinfects multidrug-resistant microbes by inducing cell surface damage. Antimicrob. Agents Chemother. 2012, 56, 2028–2036. [Google Scholar] [CrossRef] [PubMed]
- Lee, M.H.; Park, B.J.; Jin, S.C.; Kim, D.; Han, I.; Kim, J.; Hyun, S.O.; Chung, K.-H.; Park, J.-C. Removal and sterilization of biofilms and planktonic bacteria by microwave-induced argon plasma at atmospheric pressure. New J. Phys. 2009, 11, 115022. [Google Scholar] [CrossRef] [Green Version]
- Feng, H.; Sun, P.; Chai, Y.; Tong, G.; Zhang, J.; Zhu, W.; Fang, J. The interaction of a direct-current cold atmospheric-pressure air plasma with bacteria. IEEE Trans. Plasma Sci. 2009, 37, 121–127. [Google Scholar] [CrossRef]
- Pointu, A.-M.; Ricard, A.; Dodet, B.; Odic, E.; Larbre, J.; Ganciu, M. Production of active species in N2-O2 flowing post-discharges at atmospheric pressure for sterilization. J. Phys. D Appl. Phys. 2005, 38, 1905–1909. [Google Scholar] [CrossRef]
- Laroussi, M.; Minayeva, O.; Dobbs, F.C.; Woods, J. Spores survivability after exposure to low-temperature plasmas. IEEE Trans. Plasma Sci. 2006, 34, 1253–1256. [Google Scholar] [CrossRef]
- Tanino, M.; Xilu, W.; Takashima, K.; Katsura, S.; Mizuno, A. Sterilization using dielectric barrier discharge at atmospheric pressure. Int. J. Plasma Environ. Sci. Technol. 2007, 1, 102–107. [Google Scholar]
- Yang, B.; Chen, J.; Yu, Q.; Li, H.; Lin, M.; Mustapha, A.; Hong, L.; Wang, Y. Oral bacteria deactivation using a low-temperature atmospheric argon plasma brush. J. Dent. 2011, 39, 48–56. [Google Scholar] [CrossRef]
- Morfill, G.E.; Shimizu, T.; Steffes, B.; Schmidt, H.-U. Nosocomial infections–a new approach towards preventive medicine using plasmas. New J. Phys. 2009, 11, 115019. [Google Scholar] [CrossRef]
- Laroussi, M.; Mendis, D.A.; Rosenberg, M. Plasma interaction with microbes. New J. Phys. 2003, 5, 41.1–41.10. [Google Scholar] [CrossRef]
- Sato, T.; Fujioka, K.; Ramasamy, R.; Urayama, T.; Fujii, S. Sterilization efficacy of a coaxial microwave plasma flow at atmospheric pressure. IEEE Trans. Ind. Appl. 2006, 42, 399–404. [Google Scholar] [CrossRef]
- Ohkawa, H.; Akitsu, T.; Tsuji, M.; Kimura, H.; Kogoma, M.; Fukushima, K. Pulse-modulated, high-frequency plasma sterilization at atmospheric-pressure. Surf. Coat. Technol. 2006, 200, 5829–5835. [Google Scholar] [CrossRef]
- Nosenko, T.; Shimizu, T.; Morfill, G.E. Designing plasmas for chronic wound disinfection. New J. Phys. 2009, 11, 115013. [Google Scholar] [CrossRef] [Green Version]
- Pompl, R.; Jamitzky, F.; Shimizu, T.; Steffes, B.; Bunk, W.; Schmidt, H.-U.; Georgi, M.; Ramrath, K.; Stolz, W.; Stark, R.W.; et al. The effect of low-temperature plasma on bacteria as observed by repeated AFM imaging. New J. Phys. 2009, 11, 115023. [Google Scholar] [CrossRef]
- Lu, X.P.; Ye, T.; Cao, Y.G.; Sun, Z.Y.; Xiong, Q.; Tang, Z.Y.; Xiong, Z.L.; Hu, J.; Jiang, Z.H.; Pan, Y. The roles of the various plasma agents in the inactivation of bacteria. J. Appl. Phys. 2008, 104, 053309. [Google Scholar] [CrossRef]
- Laroussi, M.; Leipold, F. Evaluation of the roles of reactive species, heat, and UV radiation in the inactivation of bacterial cells by air plasmas at atmospheric pressure. Int. J. Mass Spectrom. 2004, 233, 81–86. [Google Scholar] [CrossRef]
- Ziuzina, D.; Patil, S.; Cullen, P.J.; Boehm, D.; Bourke, P. Dielectric barrier discharge atmospheric cold plasma for inactivation of Pseudomonas aeruginosa biofilms. Plasma Med. 2014, 4, 137–152. [Google Scholar] [CrossRef]
- Parkey, J.; Cross, J.; Hayes, R.; Parham, C.; Staack, D.; Sharma, A.C. A battery powered, portable, and self-contained non-thermal helium plasma jet device for point-of-injury burn wound treatment. Plasma Process. Polym. 2015, 12, 1244–1255. [Google Scholar] [CrossRef]
- Kolb, J.F.; Mattson, A.M.; Edelblute, C.M.; Hao, X.; Malik, M.A.; Heller, L.C. Cold DC-operated air plasma jet for inactivation of infectious microorganisms. IEEE Trans. Plasma Sci. 2012, 40, 3007–3026. [Google Scholar] [CrossRef]
- Ercan, U.K.; Wang, H.; Ji, H.; Fridman, G.; Brooks, A.D.; Joshi, S.G. Nonequilibrium plasma-activated antimicrobial solutions are broad-spectrum and retain their efficacies for extended period of time. Plasma Process. Polym. 2013, 10, 544–555. [Google Scholar] [CrossRef]
- Ruan, Z.; Guo, Y.; Gao, J.; Yang, C.; Lan, Y.; Shen, J.; Xu, Z.; Cheng, C.; Liu, X.; Zhang, S.; et al. Control of multidrug-resistant planktonic Acinetobacter baumannii: Biocidal efficacy study by atmospheric-pressure air plasma. Plasma Sci. Technol. 2018, 20, 065513. [Google Scholar] [CrossRef]
- Yeom, J.; Shin, J.-H.; Yang, J.-Y.; Kim, J.; Hwang, G.-S. 1H NMR-based metabolite profiling of planktonic and biofilm cells in Acinetobacter baumannii 1656-2. PLoS ONE 2013, 8, e57730. [Google Scholar] [CrossRef]
- Gazeli, K.; Nöel, C.; Clément, F.; Dauge, C.; Svarnas, P.; Belmonte, T. A study of helium atmospheric-pressure guided streamers for potential biological applications. Plasma Sources Sci. Technol. 2013, 22, 025020. [Google Scholar] [CrossRef]
- Monge-Daugé, C.; Clément, F.; Svarnas, P.; Loiseau, J.-F.; Ricard, A.; Held, B. Experimental study coupled with electrical modeling for the consideration of DBD-based plasma jet. IEEE Trans. Plasma Sci. 2012, 40, 2254–2260. [Google Scholar] [CrossRef]
- Cardoso, R.P.; Belmonte, T.; Keravec, P.; Kosior, F.; Henrion, G. Influence of impurities on the temperature of an atmospheric helium plasma in microwave resonant cavity. J. Phys. D Appl. Phys. 2007, 40, 1394–1400. [Google Scholar] [CrossRef]
- Alkawareek, M.Y.; Algwari, Q.T.; Gorman, S.P.; Graham, W.G.; O’Connell, D.; Gilmore, B.F. Application of atmospheric pressure nonthermal plasma for the in vitro eradication of bacterial biofilms. FEMS Immunol. Med. Microbiol. 2012, 65, 381–384. [Google Scholar] [CrossRef] [Green Version]
- Katsikogianni, M.; Spiliopoulou, I.; Dowling, D.P.; Missirlis, Y.F. Adhesion of slime producing Staphylococcus epidermidis strains to PVC and diamond-like carbon/silver/fluorinated coatings. J. Mater. Sci. Mater. Med. 2006, 17, 679–689. [Google Scholar] [CrossRef]
- Barekzi, N.; Laroussi, M. Dose-dependent killing of leukemia cells by low-temperature plasma. J. Phys. D Appl. Phys. 2012, 45, 422002. [Google Scholar] [CrossRef]
- Yoon, S.-Y.; Kim, K.-H.; Seol, Y.-J.; Kim, S.-J.; Bae, B.; Huh, S.-R.; Kim, G.-H. Effects of metastable species in helium and argon atmospheric pressure plasma jets (APPJs) on inactivation of periodontopathogenic bacteria. J. Korean Phys. Soc. 2016, 68, 1176–1191. [Google Scholar] [CrossRef]
- Laroussi, M. Nonthermal decontamination of biological media by atmospheric-pressure plasmas: Review, analysis and prospects. IEEE Trans. Plasma Sci. 2002, 30, 1409–1415. [Google Scholar] [CrossRef]
- Mendis, D.A.; Rosenberg, M.; Azam, F. A note of the possible electrostatic disruption of bacteria. IEEE Trans. Plasma Sci. 2000, 28, 1304–1306. [Google Scholar] [CrossRef]
- Zimmermann, J.L.; Shimizu, T.; Schmidt, H.U.; Li, Y.F.; Morfill, G.E.; Isbary, G. Test for bacterial resistance build-up against plasma treatment. New J. Phys. 2012, 14, 073037. [Google Scholar] [CrossRef] [Green Version]
- Sun, B.; Sato, M.; Clements, J.S. Use of a pulsed high-voltage discharge for removal of organic compounds in aqueous solution. J. Phys. D Appl. Phys. 1999, 32, 1908. [Google Scholar] [CrossRef]

© 2019 by the authors. Licensee MDPI, Basel, Switzerland. This article is an open access article distributed under the terms and conditions of the Creative Commons Attribution (CC BY) license (http://creativecommons.org/licenses/by/4.0/).
Share and Cite
Svarnas, P.; Spiliopoulou, A.; Koutsoukos, P.G.; Gazeli, K.; Anastassiou, E.D. Acinetobacter baumannii Deactivation by Means of DBD-Based Helium Plasma Jet. Plasma 2019, 2, 77-90. https://doi.org/10.3390/plasma2020008
Svarnas P, Spiliopoulou A, Koutsoukos PG, Gazeli K, Anastassiou ED. Acinetobacter baumannii Deactivation by Means of DBD-Based Helium Plasma Jet. Plasma. 2019; 2(2):77-90. https://doi.org/10.3390/plasma2020008
Chicago/Turabian StyleSvarnas, Panagiotis, Anastasia Spiliopoulou, Petros G. Koutsoukos, Kristaq Gazeli, and Evangelos D. Anastassiou. 2019. "Acinetobacter baumannii Deactivation by Means of DBD-Based Helium Plasma Jet" Plasma 2, no. 2: 77-90. https://doi.org/10.3390/plasma2020008





